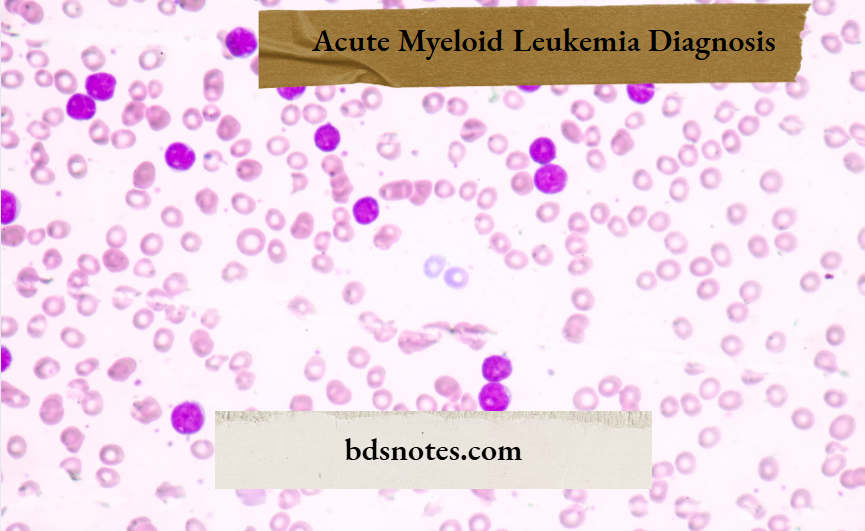
Acute Myeloid Leukemia Diagnosis

Acute Myeloid Leukemia (AML): Clinical Features and Diagnostic Insights
Question. Write a short note on the clinical features and diagnosis of acute myeloid leukaemia.
Answer.
Clinical Features of acute Myeloid leukaemia
- It occurs in adults, and it ages range from 15 to 40 years.
- It accounts of 20% of childhood leukaemia.
- Symptoms due to anemia, i.e. tiredness, weakness and marked pallor.
- Haemorrhagic manifestations: Petechiae, bleeding from gums and nose, persistent bleeding after tooth extraction.
- Infection: It causes infectious lesions of the mouth and throat,i.e. ulceration of the mouth and pharynx, herpes simplex
infection of the face, and infection of the respiratory tract, such as bronchitis and pneumonia. - Symptoms of cellular hyperviscosity
- There are tissue deposits of leukemic cells causing gum hypertrophy, which is common in the myelomonocytic and monocytic variety of AML.
- Lymphadenopathy and splenomegaly are present
- Signs of organ infiltration are present, i.e.
Skin: Bluish nodules or dusky red patches are present.
Kidneys: Presence of kidney failure.
Other sites: Testes, ovary, liver, gut, and serous membranes such as pleura and peritoneum. - Bone pain is present, i.e. tenderness of the sternum, osteolytic bone lesions, and pathologic fractures may occur.
- Constitutional symptoms, i.e,. Fever, malaise, and prostration.
- Roth’s spot, i.e. presence of white central retinal haemorrhages in acute myeloid leukaemia
Acute Myeloid Leukemia (AML): Clinical Features and Diagnosis
Diagnosis of acute Myeloid leukemia
Clinical Features of Acute Myeloid Leukemia (AML)
- The peripheral blood picture shows an increase in several typical or atypical myeloblasts. Auer rods may be found in the cytoplasm.
- Bone marrow aspirate shows more than 30% blast cells. Marrow is entirely replaced by myeloblasts and promyelocytic.
- There is presence of low to high WBC count.
- Thrombocytopenia is moderate.
- Cytochemical stains: Myeloperoxidase and Sudan black are positive.
Leave a Reply